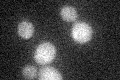
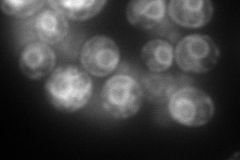

View description
Alpha 1,3 glucosyltransferase, involved in transfer of oligosaccharides from dolichyl pyrophosphate to asparagine residues of proteins during N-linked protein glycosylation; mutations in human ortholog are associated with disease
Localization:
Intensity:
Fold change:
Significance:
-
C’ GFP library in SD
below threshold18 -
N' NOP1pr-GFP in SD

ER115.122 -
N' TEF2pr-mCherry in SD
ER,vacuole175.585 -
N' NATIVEpr-GFP in SD

punctate19.3771 -
N' TEF2pr-VC and Cyto-VN in SD

ER38.5242 -
C’ GFP library in SD+DTT

cytosol15.70.87No -
C’ GFP library in SD+H2O2

cytosol16.70.92No -
C’ GFP library in Starvation Media

cytosol14.10.78No -
C’ GFP library on the background of Pup2-DaMP

below threshold -
C’ GFP library on the background of CCT mutant

below threshold18.39641.02182No
